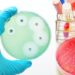

Эвобрутиниб, экспериментальный ингибитор BTK, разрабатываемый для людей с рецидивирующими формами рассеянного склероза (РС), по-прежнему хорошо переносится и демонстрирует низкую частоту рецидивов после четырех лет лечения.
Это согласно новым данным, охватывающим исследование фазы 2 (NCT02975349), в котором эвобрутиниб сравнивался с плацебо и одобренным средством для лечения рассеянного склероза Tecfidera (диметилфумарат), а также открытое расширенное исследование, в котором все участники получали эвобрутиниб.
Новые результаты будут представлены сегодня на Форуме Американского комитета по лечению и исследованиям рассеянного склероза (ACTRIMS) 2023, 23-25 февраля виртуально и в Сан-Диего, Калифорния.
Плакат под названием “Эффективность и безопасность ингибитора тирозинкиназы Брутона эвобрутиниба при рецидивирующем рассеянном склерозе в течение 3,5 лет лечения: продолжение открытой фазы II” был подготовлен исследователями Merck KGaA (известной в Северной Америке как EMD Serono), компании, разрабатывающей эвобрутиниб.
“Эти новые долгосрочные данные дополняют ранее представленные данные, демонстрирующие влияние эвобрутиниба на новые маркеры, указывающие на прогрессирование независимо от рецидива, такие как медленно расширяющиеся поражения. В совокупности эти данные подчеркивают потенциал эвобрутиниба в качестве безопасного и высокоэффективного лечения для людей, живущих с [рецидивирующим рассеянным склерозом] ”, — сказал Ян Клатт, старший вице-президент и руководитель отдела неврологии и иммунологии Merck, в пресс-релизе компании.
Эвобрутиниб — это исследуемый пероральный препарат, предназначенный для блокирования белка тирозинкиназы Брутона (BTK), который необходим для выживания и функционирования В—клеток — иммунных клеток, участвующих в развитии рассеянного склероза. Ожидается, что он ослабит воспаление и замедлит прогрессирование заболевания за счет уменьшения количества В-клеток и снижения активации других типов иммунных клеток.
В клиническом исследовании фазы 2 приняли участие 267 пациентов либо с рецидивирующе-ремиттирующим рассеянным склерозом (RRMS), либо с активным вторично прогрессирующим рассеянным склерозом (SPMS).
Эффективность, безопасность эвобрутиниба
Участники были случайным образом распределены на одну из пяти групп. Три группы получали эвобрутиниб в разных дозах — 25 мг один раз в день, 75 мг один раз в день или 75 мг два раза в день. Две другие группы получали плацебо или Текфидеру и использовались в качестве контроля.
Участники групп эвобрутиниба и Текфидеры получали назначенное лечение в течение 48 недель (почти год), в то время как участники группы плацебо получали его в течение 24 недель, а затем были переведены на 25 мг эвобрутиниба.
Результаты исследования показали, что двукратная суточная доза эвобрутиниба в дозе 75 мг значительно снизила активность заболевания рассеянным склерозом через 24 недели, при этом у пациентов значительно уменьшилось количество поражений с активным воспалением и частота рецидивов по сравнению с пациентами, принимавшими плацебо.
После года лечения у пациентов с более высокой дозой было в среднем 0,11 рецидива в год, в то время как у пациентов, получавших плацебо, было 0,37 рецидива в год в течение первых 24 недель до перехода на эвобрутиниб.
После завершения плацебо-контролируемой части участникам было предложено присоединиться к расширению открытого исследования, в котором все получали в среднем 75 мг эвобрутиниба один раз в день в течение года, прежде чем перейти на дозу 75 мг два раза в день.
Данные, опубликованные на форуме ACTRIMS, охватывающие 228 недель в ходе испытаний и продления, показали, что частота рецидивов продолжала снижаться после четырех лет лечения.
Независимо от назначенного лечения в рандомизированной части, у пациентов наблюдалось в среднем 0,13 рецидива в год в течение четырех лет. Начальный показатель в расширенной части составлял 0,19 рецидива в год при приеме 75 мг эвобрутиниба один раз в день, но он снизился еще больше до 0,1 рецидива в год после перехода на 75 мг два раза в день.
Частота рецидивов оставалась низкой у тех, кто получал самую высокую дозу с самого начала — 0,12 рецидива в год на 228-й неделе.
Эвобрутиниб продолжал хорошо переноситься в течение четырех лет. Большинство побочных эффектов были легкими или умеренными, у семи пациентов (3,3%) был серьезный побочный эффект, вызванный лечением. Не было увеличения побочных эффектов после того, как пациенты перешли на самую высокую дозу в расширенной части.
Два текущих исследования фазы 3 — EVOLUTION RMS1 (NCT04338022) и EVOLUTION RMS2 (NCT04338061) — сравнивают безопасность и эффективность эвобрутиниба с Aubagio (терифлуномидом), одобренным методом лечения рассеянного склероза, у более чем 1800 участников.
“Мы с нетерпением ждем представления подробных результатов наших полностью зарегистрированных клинических испытаний III фазы в ближайшем будущем”, — сказал Клатт.